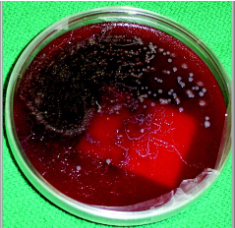
<ul><li><p>Look for rhabditiform larvae in concentrated fecal specimens</p><ul><li><p>Must differentiate from hookworm larvae</p></li></ul></li><li><p><strong><u>Very rarely will you ever see eggs</u></strong></p><ul><li><p>Would indicate hyper-infection</p></li></ul></li><li><p>May see "trails" on your stool culture agar plates--result of migrating larvae from the stool thru the bacterial colonies</p></li></ul><p></p>

(nematodes) helminths quiz - microbio II (cls 542)
1/59
There's no tags or description
Looks like no tags are added yet.
Name | Mastery | Learn | Test | Matching | Spaced |
|---|
No study sessions yet.
60 Terms
general characteristics of nematodes
Multicellular & nonsegmented
Bilateral symmetry
Organisms with body shapes that are mirror images along a midline called the sagittal plane
internal organs are not necessarily distributed symmetrically
Some do not need an intermediate host
Two sexes: female is larger than male
Males have curled posterior ends and die following copulation (losers)
Four larval stages
Infective stage is usually the 3rd larval stage
how to diagnose a nematode infection?
Diagnosis is by finding characteristic eggs in the feces
EXCEPT for Strongyloides and pinworms (Enterobius)
Can see Strongyloides in sputum
Worm burden does not correlate with symptomology
(hookworm) necator americanus
AKA new world hookworm
Distribution: Southern US, Appalachia
Prefers sandy, moist, shaded soil
1865-1910 estimated 40% of the population of US South suffered from hookworm disease
Rockefeller Foundation Public Health Campaign
Associated with stereotypes of stupid Southerner

(hookworm) ancylostoma duodenale
aka old world hookworm
Not found in US but range overlaps with Necator americanus

hookworm life cycle
unembryonated eggs are passed in feces
develop into rhabditiform larvae (1-2 days)
rhabditiform → filariform larva (lives 3-4 weeks in soil)
filariform penetrates skin of definitive host
larvae migrate to lungs; coughed up and swallowed
mature into adults in gut
adults live in small intestine

symptoms of hookworm infection
Itching at site of skin penetration & edema
Filariform larvae penetrate skin
Pulmonary symptoms once they reach the lungs
Eosinophilia seen
GI stage:
Chronic blood loss causing IDA--worms ingest blood
Protein malnutrition
Growth and mental retardation with lethargy
hookworm disease
Pathogenesis & degree of anemia is directly related to worm burden
Worm produces anticoagulant--enhances bleeding
Risk factors:
Living in rural areas
Poor sanitation; no access to clean water
Low income & educational attainment
Bare feet
Treated with Albendazole
diagnosis of hookworm infection (egg characteristics)
60 x 40 um eggs
Smaller than Trichostrongylus spp
Thin, smooth, transparent, colorless shells
Yolk cells retract leaving clear space
Often difficult to see

definitive speciation of hookworm is done by what?
Gold standard = microscopy
Must find adult worm and observe buccal cavity
Molecular techniques available for speciation
difference between ancylostoma teeth & necator teeth?
ancylostoma = pointy teeth
necator = cutting plates / looks like manatee

normally, you should NOT see hookworm larvae in a properly collected fecal sample. name situations where larvae could be seen in a sample that also contains hookworm eggs? (3)
A dual infection with another nematode (most likely Strongyloides)
The specimen has sat out at room temperature for more than 24 hrs and the hookworm eggs have hatched, so you will see both eggs and larvae
Severe Strongyloides infection where diarrhea is so bad both eggs and larvae are passed (yeowch)
trichostrongylus
Worldwide distribution
Where herbivores animals are raised
Common parasite of herbivores
Usually does not cause problems for humans, actually a rare infection
Acquired by ingestion of filariform larvae on contaminated vegetation
Highest prevalence rates in individuals from regions with poor sanitary conditions, in rural areas, or who are farmers/herders
trichostrongylus eggs
Must differentiate from hookworm eggs
78-98 x 40-50 um
Larger, elongated compared to hookworm
Slightly pointed

life cycle of trichostrongylus
eggs are passed in feces
rhabditiform larvae hatches from egg
rhabditiform → filariform in the environment (exists on vegetation)
humans ingest filariform larvae on contaminated vegetation
adults live in small intestine

strongyloides stercoralis
Wide distribution in the tropics and subtropics, extending into the moist temperate regions
In south US and Appalachia
100-200 million worldwide affected
Usually asymptomatic infections, but can cause problems when and infected person becomes immunocompromised
Infections can last decades with no symptoms
Pathogenesis
life cycle of strongyloides stercoralis (general)
Acquired by direct skin penetration or by ingestion of contaminated water (filariform larvae)
Attracted to humans by chemical found on the skin, especially the feet
Urocanic acid
Migrate via the blood stream to the alveoli of the lungs
Coughed up and swallowed

steps of s stercoralis life cycle
infective filariform larvae penetrate skin
autoinfection
filariform enter circulation or lungs where they are swallowed & enter small intestine
become adults in gut; adult female worm creates eggs in intestinal mucosa
eggs hatch into rhabditiform & develop into filariform & restart cycle
free-living
rhabditiform excreted in stool
develop into mature free living worms
worms make eggs & eggs r fertilized → rhabditiform hatch
rhabditiform → filariform → penetrate skin
(strongyloides stercoralis) autoinfection life cycle
Eggs laid in gut hatch into rhabditiform larvae
Mature into filariform larvae
Penetrate intestine, migrate to lung
Asexual reproduction
Only female worms present

(strongyloides stercoralis) free living life cycle
Rhabditiform larvae mature into 4th stage larvae, then adults
Mate, lay eggs, hatch rhabditiform
Larvae mature into filariform larvae that mature into adults
Sexual reproduction
Occurs in temperate climates

(strongyloides stercoralis) parasitic life cycle
Rhabditiform larvae hatch from egg, mature into filariform larvae
Penetrate intact skin of human host
Moves into the auto-infective cycle from there

rhabditiform vs filariform
Rhabditiform = Released from Human = baby worm (smaller)
Filariform = Free-living Infective = adult worm
symptoms of strongyloides stercoralis infection
Wide variety of severity
Cutaneous--migrating, urticarial rash
Pulmonary--cough, wheezing, shortness of breath, resembles asthma
Intestinal--diarrhea, cramping, bloating, anorexia, abdominal pain and tenderness
Eosinophilia usually seen
diagnosis of strongyloides stercoralis
Look for rhabditiform larvae in concentrated fecal specimens
Must differentiate from hookworm larvae
Very rarely will you ever see eggs
Would indicate hyper-infection
May see "trails" on your stool culture agar plates--result of migrating larvae from the stool thru the bacterial colonies

strongyloides stercoralis rhabditiform larvae
Short and sexy
first-stage larva as passed in the feces
esophagus is short (much less than 40% of the body) and distinctly bulbed, the short mouth capsule, and the large genital rudiment (GR)
the latter 2 characteristics distinguish these larvae from those of the hookworms
simple pointed tail

strongyloides stercoralis filariform larvae
esophagus extends to 40% of the body length
Focus carefully to notice the notched tail
Length of esophagus and the notch in the tail allow you to distinguish between the two larval forms
The esophagus does not have a bulb

hookworm rhabditiform larvae
Long buccal cavity
More than the width of the body
Genital primordium NOT visible
Esophagus is bulbed

strongyloides rhab vs filariform
rhabditiform: short buccal cavity; esophageal bulb; pointed tail; large genital primoridum
filariform: short buccal cavity; no esophageal bulb; notched tail

hookworm rhab vs filariform
rhabditiform: long buccal cavity; esophageal bulb; straight tail; small genital primordium
filariform: long buccal cavity; no esophageal bulb; pointed tail

strongyloides rhab vs hookworm rhab
strongyloides: short buccal cavity; esophageal bulb; pointed tail
hookworm: long buccal cavity; esophageal bulb; straight tail

strongyloides filariform vs hookworm filariform
strongyloides: short buccal cavity; no esophageal bulb; notched tail
hookworm: long buccal cavity; no esophageal bulb; pointed tail

enterobius vermicularis
AKA pinworm
Adult female: 8-13 mm
Most children get from: family pet or daycare (group infections common)
Worldwide with incidence probably underestimated
Most common in cool and temperate regions
transmission & symptoms of enterobius vermicularis
Transmitted via hands or fomites to mouth
Highly infectious; eggs stay infective for a long time
Symptoms: localized inflammation, itching, vaginitis, insomnia, irritability; possible secondary bacterial infection if itching becomes intense
life cycle of enterobius vermicularis
gravid female migrates to perianal region to lay eggs at night
embryonated eggs on perianal folds
larvae mature w/in 4-6 hrs
embryonated eggs ingested by human (no intermediate host)
larvae hatch in small intestine
adults live in lumen of cecum (need female & male for reproduction)

enterobius vermicularis eggs
30 x 50 um ; embryonated
Thin, smooth, transparent shell
Oval and asymmetrical with one side flattened (looks like deflated football)
Usually contain a well-developed larvae

ascaris lumbricoides
Largest intestinal nematode
Worldwide distribution
Illness is generally benign
Can have intestinal blockage if worm burden is heavy
Can develop hepatitis and pneumonitis from the larvae
In heavy infestations, the worms may crawl of the anus, nares, or mouth, and young worms may be passed in the stools
life cycle of ascaris lumbricoides
feces with ascaris eggs exposed to environment
unfertilized eggs will not undergo development into adult worm
fertile egg goes through multiple developmental stages
eventually becomes an embryonated egg w L3 larvae (infectious form)
definitive host ingests embryonated eggs
larvae coughed up and swallowed & maturation continues in small intestine
adults inhabit small intestine

key info about ascaris lumbricoides life cycle
Eggs immature when passed
Mature in environment
Ingested, hatch in gut
Larvae migrate to lungs
Coughed up and swallowed
Mature into adults in gut
unfertilized ascaris eggs
90 x 40 um
Oval, yellow brown stained
Thick shell, may be corticated (albuminous coating)
Undifferentiated internal material
If only see these, the host is only infected with FEMALE worms

fertile ascaris eggs
45 x 60 um
Yellow brown
Thick transparent shell
May have cortication
Cleavage of internal yolk will be seen; sometimes formed larvae seen inside eggs

trichuris trichiura
Worldwide distribution--mostly in hot, moist regions
Very common--may find in specimens used in lab
Heavier infections may cause diarrhea or dysentery with cramps and occasional rectal prolapse
Dehydration, weight loss and anemia may occur
IDA due to bleeding from the site of attachment, not ingestion of blood by the worm
trichuris symptoms
Light infections usually asymptomatic
Heavy infections:
Diarrhea
Cramps
Rectal prolapse
Iron deficiency anemia
life cycle of trichuris trichiura
unembryonated eggs passed in feces
goes through 2 cell stages & eventually advanced cleavage
ingestion of embryonated eggs by definitive host
larvae hatch in small intestine
adults live in cecum of intestine

trichuris trichiura eggs
54 x 22 um
Distinct barrel shape
Refractile, convex, hyaline polar plugs at both ends
Unembryonated internal mass

capillaria philippinensis
Found primarily in Philippines and Thailand, and less frequently in Japan, Egypt, and Iran
Humans acquire infection by ingesting undercooked infected fish containing the larval form
Incubation period is about 1 month
To diagnose: find the eggs feces
When chronic diarrhea is present, eggs, larvae and adult worms may be passed simultaneously in the feces
Chronic form leads to hepatitis with eosinophilia & liver dysfunction
life cycle of capillaria philippinensis
unembryonated, thick shelled eggs are passed in feces
eggs embryonated in water
infective larvae develop in tissue of intermediate host (fish)
humans ingest raw/undercooked fish
larvae mature into adults in small intestinal mucosa
females will produced unembryonated eggs (passed in feces) & embryonated eggs that hatch in definitive host
larvae re-invade small intestinal mucosa in autoinfection

capillaria philippinensis eggs
Must not confuse with Trichuris eggs
35-45 x 20-25 um
More squarish than Trichuris eggs
Less conspicuous polar plugs
Flatter and less prominent
Thick striated shell

answer the following about hookworm:
What form is shed/acquired from the human?
If, an egg, is it embryonated or not?
If it is a larvae, what kind of larvae?
What hatches from the egg?
unembryonated eggs pass in feces
rhabditiform larvae hatch from eggs within 1-2 days
answer the following about hookworm:
intermediate host? reservoir host?
What is the infective stage that gets back into the human?
How does the infective stage get back into the human?
General info about what happens once it gets back into the human.
Where do adults live?
intermediate: none ; reservoir: humans
infective: filariform larvae
direct skin penetration
larvae migrate to lungs and are coughed up, swallowed, and mature into adults in the gut
adults live in small intestine
answer the following about trichostrongylus:
What form is shed/acquired from the human?
If, an egg, is it embryonated or not?
If it is a larvae, what kind of larvae?
What hatches from the egg?
humans shed unembryonated eggs in feces
rhabditiform larvae hatch from egg & matures into filariform in the environment (trichostrongylus)
answer the following about trichostrongylus:
intermediate host? reservoir host?
What is the infective stage that gets back into the human?
How does the infective stage get back into the human?
General info about what happens once it gets back into the human.
Where do adults live?
intermediate: none ; reservoir: large herbivoires (sheep/cattle)
infective stage: filariform larva
humans ingest filariform on contaminated vegetation NOT skin penetration
develop into adults & live in the small intestine
answer the followng abt s stercoralis:
What form is shed/acquired from the human?
If, an egg, is it embryonated or not?
If it is a larvae, what kind of larvae?
What hatches from the egg?
rhabditiform larvae in intestine are excreted in stool
eggs hatch into rhabditiform larvae after being fertilized by female worms in the environment or in the intestine
answer the following abt s stercoralis:
intermediate host? reservoir host?
What is the infective stage that gets back into the human?
How does the infective stage get back into the human?
General info about what happens once it gets back into the human.
Where do adults live?
intermediate: none ; reservoir: dogs/cats/humans
infective stage: filariform larvae
direct skin penetration
filariform go to lungs and are swallowed, reaching the small intestine where they become adults
adults live in large intestine
answer the following about e vermicularis:
What form is shed/acquired from the human?
If, an egg, is it embryonated or not?
If it is a larvae, what kind of larvae?
What hatches from the egg?
embryonated eggs are “shed” from human (female lays them there at night)
larva hatches from the egg after it is consumed by humans
answer the following about e vermicularis:
intermediate host? reservoir host?
What is the infective stage that gets back into the human?
How does the infective stage get back into the human?
General info about what happens once it gets back into the human.
Where do adults live?
intermediate: none ; reservoir: dogs/humans
infective stage: embryonated eggs
humans ingest embryonated eggs/come into contact w them through bedsheets or pets
eggs hatch in larvae in small intestine
adults live in lumen of cecum
answer the following about a lumbricoides:
What form is shed/acquired from the human?
If, an egg, is it embryonated or not?
If it is a larvae, what kind of larvae?
What hatches from the egg?
can shed both unembryonated/embryonated eggs in feces
infective larvae hatches from the egg (happens in the human)
answer the following abt a lumbricoides:
intermediate host? reservoir host?
What is the infective stage that gets back into the human?
How does the infective stage get back into the human?
General info about what happens once it gets back into the human.
Where do adults live?
no intermediate/reservoir host—completes its life cycle in humans
infective stage: fertilized ascaris egg embryonated w L3 larva
humans ingest fertilized egg
egg hatches & matures into an adult worm in the small intestine
adults live in the small intestine
answer the following about t trichiura:
What form is shed/acquired from the human?
If, an egg, is it embryonated or not?
If it is a larvae, what kind of larvae?
What hatches from the egg?
unembryonated egg shed from human
goes through two-cell stage and hatches into larvae AFTER human has ingested the embryonated eggs
answer the following about t trichiura:
intermediate host? reservoir host?
What is the infective stage that gets back into the human?
How does the infective stage get back into the human?
General info about what happens once it gets back into the human.
Where do adults live?
no intermediate host; reservoir: humans/primates
infective stage: embryonated egg
humans ingest embryonated egg from contaminated food/water
larvae hatch in small intestine
adults live in the cecum
answer the following about c philippinensis:
What form is shed/acquired from the human?
If, an egg, is it embryonated or not?
If it is a larvae, what kind of larvae?
What hatches from the egg?
unembryonated eggs shed from the human
infective larvae hatch from eggs in intermediate host tissue
answer the following about c philippinensis:
intermediate host? reservoir host?
What is the infective stage that gets back into the human?
How does the infective stage get back into the human?
General info about what happens once it gets back into the human.
Where do adults live?
intermediate: fish ; reservoir: humans/fish
infective stage: larvae inside intermediate host
humans ingest raw/undercooked fish
larvae develops into adults and contribute to auto-infective cycle (need 2 worms to fertilize eggs)
adults: small intestinal mucosa